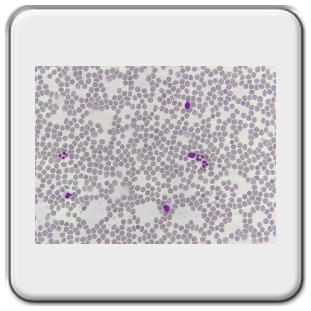
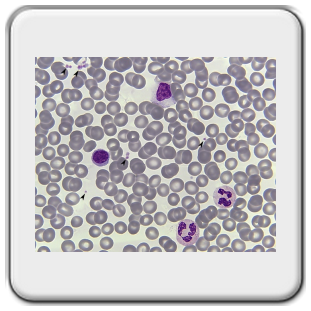
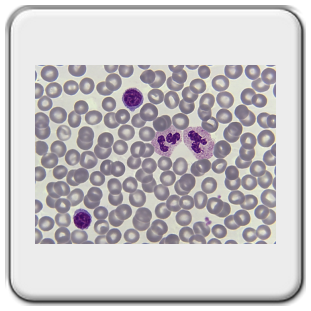
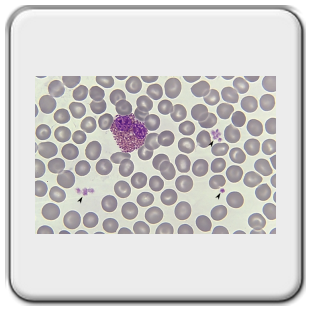
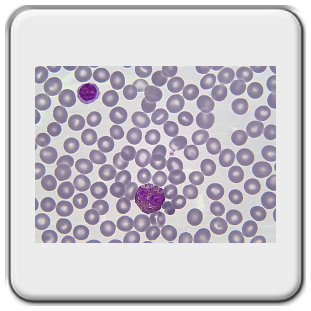
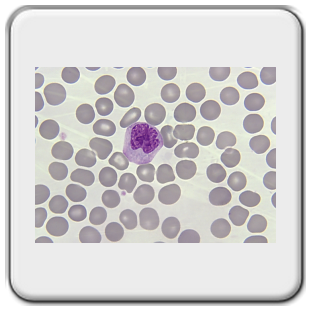
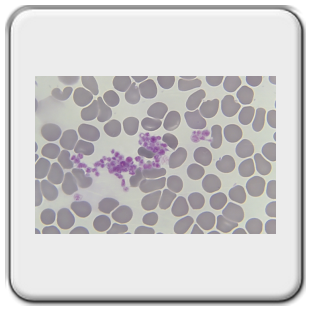
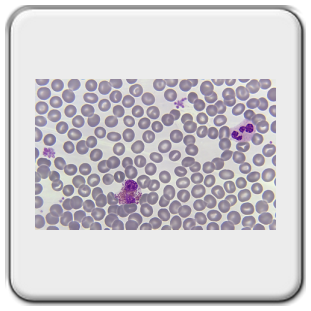
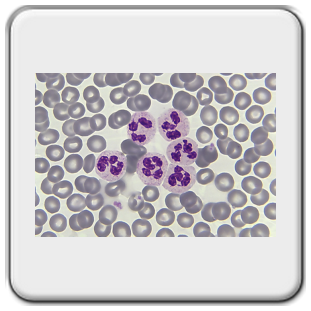
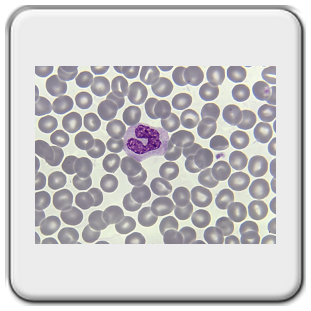
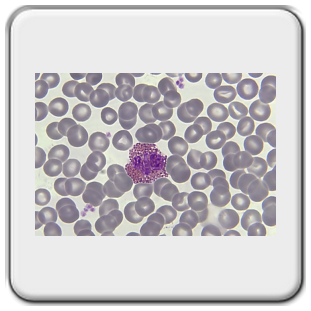
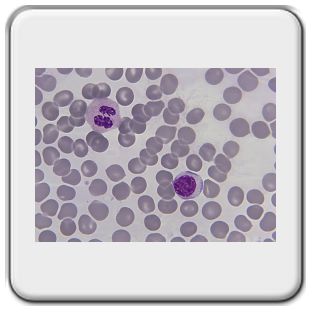

Bloedcellen van de mens,
Doel van preparaat: Uitstrijk maken van menselijk bloed, preparaat kleuren en de verschillende bloedcellen benoemen.
Inleiding[1],
Bloed is een vloeistof waarin cellen zijn gesuspendeerd; het bevindt zich in een gesloten circulatiesysteem, waar het -door de ritmische contracties van het hart- in één richting doorheen stroomt. Bloed kan beschouwd worden als een bijzondere vorm van bindweefsel met vloeibare tussenstof. Bloed bestaat uit een vloeibare fase, het bloedplasma en de bloedcellen, te weten:
- de erytrocyten of rode bloedcellen;
- de leukocyten of witte bloedcellen;
- de trombocyten of bloedplaatjes.
Wanneer bloed buiten het circulatiesysteem komt, stolt het, waarbij fibrinogeen uit het bloedplasma een netwerk van fibrinevezels vormt, waarin de bloedcellen gevangen worden. De heldere vloeistof die vrijkomt naarmate de stolling voortschrijdt, heet serum. Serum verschilt van bloedplasma doordat de stollingseiwitten eruit verwijderd zijn. Bloed dat door anticoagulantia (heparine, citraat, enzovoort) onstolbaar is gemaakt, wordt bij centrifugeren in drie lagen gescheiden. De verhoudingen van het volume van de cellen (hoofdzakelijk erytrocyten) tot het totale bloedvolume noemt men de hematocriet.
Normaalwaarden zijn: 40 a 50% bij mannen, 35 a 45% bij vrouwen, ongeveer 35% bij kinderen tot tien jaar en 45 a 60% bij pasgeborenen. Boven in de hematocrietbuis verzamelt zich het bloedplasma. Het is een doorzichtige, soms iets gelige, licht viskeuze vloeistof. Onder in de hematocrietbuis bevinden zich de bloedcellen, die in twee lagen gescheiden zijn. De onderste laag is rood en bestaat uitsluitend uit erytrocyten. De dunne hierboven gelegen laag is grijswit en bestaat uit leukocyten. Deze wordt als buffy coat aangeduid. De scheiding komt tot stand doordat de leukocyten een geringere dichtheid hebben dan de erytrocyten. Boven de laag leukocyten bevindt zich een laagje trombocyten, dat onder normale omstandigheden niet met het blote oog zichtbaar is.

- Erytrocyten[1]
De erytrocyten (rode bloedcellen) zijn vooral betrokken bij het transport van O2 en CO2. Dit geschiedt in hoofdzaak door binding aan het hemoglobine in de erytrocyten. Daarnaast kan CO2 ook binden aan de andere eiwitten van de erytrocyten en bevindt het zich in opgeloste vorm in het plasma, als CO2 of HCO3-. Zoogdiererytrocyten hebben geen kern; bij de mens zijn het biconcave schijfjes met een doorsnede van gemiddeld 7,5um. Waarnemingen in vivo (in het levende wezen) hebben aangetoond dat een erytrocyt in een nauwe capillair (kleinste bloedvat in het lichaam) of bij het passeren van een vertakking in het capillaire stelsel een sterke vervorming ondergaat, waarbij hij vaak komvormig wordt. Aangezien erytrocyten gemakkelijk vervormbaar zijn, blijft de viscositeit van het bloed als geheel vrij laag, ondanks het feit dat het voor bijna de helft uit cellen bestaat.
- Leukocyten[1]
De witte bloedcellen (leukocyten) kunnen als volgt worden ingedeeld.
Granulocyten en agranulocyten (bepalend is de aanwezigheid van granulaat).
TEM opname van een erytrocyt. Links origineel, rechts ingekleurd met Fotoshop.
Opname van Carsten Dittmayer, Universiteit van Berlijn.
Klik op de afbeelding voor een vergroting.
Tot de granulocyten kunnen worden gerekend: | Tot de agranulocyten worden gerekend: |
A. neutrofiele granulocyten | D. monocyten |
B. eosinofiele granulocyten | E. lymfocyten |
C. basofiele granulocyten |
A. Neutrofiele granulocyt[1]
Neutrofiele granulocyten ontwikkelen zich in het beenmerg en worden bij een zekere rijpingsgraad aan de circulatie afgegeven. De kernen van alle granulocyten hebben een wandstandig chromatinepatroon (chromatine ligt tegen de wand van de kern). Bij een neutrofiel bestaat de kern uit 2 tot 5 segmenten verbonden door chromatinebruggen. Het aantal segmenten loopt parallel met de  leeftijd van de cel. Bij hypersegmentie heeft het merendeel van de neutrofielen meer dan 5 segmenten. Bij bepaalde anomalieën (afwijkingen) kan dit ook bij jonge cellen optreden. Bij vrouwen kan het inactieve X-chromosoom zichtbaar zijn als een uitsteeksel van een van de kernlobben (drumstick-fenomeen, lichaampje van Barr). Een onrijpe neutrofiel heeft een staafkern (hoefijzer vorm).
leeftijd van de cel. Bij hypersegmentie heeft het merendeel van de neutrofielen meer dan 5 segmenten. Bij bepaalde anomalieën (afwijkingen) kan dit ook bij jonge cellen optreden. Bij vrouwen kan het inactieve X-chromosoom zichtbaar zijn als een uitsteeksel van een van de kernlobben (drumstick-fenomeen, lichaampje van Barr). Een onrijpe neutrofiel heeft een staafkern (hoefijzer vorm).
B. Eosinofiele granulocyten[1]
Het heeft een karakteristieke tweelobbige kern. ER, mitochondriën en Golgi-apparaat zijn in de rijpe cel weinig ontwikkeld. In het cytoplasma zitten grote ovale specifieke granula (200 per cel) die sterk met eosine kleuren. Het internum bevat het major basic protein (MBP), dit vormt 50% van het totale eiwit van de granula. Het speelt een belangrijke rol bij het doden van wormen en parasieten. Eosinofielen zijn van belang bij het fagocyteren en opruimen van antigeen-antilichaamcomplexen die zijn gevormd als onderdeel van een allergische reactie.
C. Basofiele granulocyten[1]
De kern is in onregelmatige lobben verdeeld en wordt meestal overschaduwd door de talrijke en relatief grote specifieke granula. De korrels zijn onregelmatig van vorm en grootte en tonen een metachromatische kleurreactie. De granula worden door een membraan omgeven en bevatten heparine (zuur) en histamine. Basofielen kunnen leukotriënen genereren, die een trage contractie van glad spierweefsel veroorzaken.
D. Monocyten[1]
De grote kern is nier- tot hoefijzervormig en meestal excentrisch gelegen. Het chromatine is veel fijner verdeeld dan bij de lymfocyt en bevat 2 à 3 nucleoli. Het cytoplasma is licht basofiel en bevat kleine niet-specifieke azurofiele granula (lysosomen). Het heeft een matig ontwikkeld ruw ER, vrije polyribosomen, goed ontwikkeld Golgi-complex (aanmaak lysosomale granula), kleine, langwerpige mitochondriën en verspreide microvilli en pinocytose blaasjes aan het celoppervlak. Ze komen voor in het perifere bloed, bindweefsel en lichaamsholten en behoren tot het mononucleaire fagocytensysteem. Via diapedese dringen ze door de wand van capillairen en venulen, waarna zij in het bindweefsel tot actieve macrofagen differentiëren. Hierbij neemt het volume en het aantal lysosomen toe. De halfwaardetijd in het perifere bloed bedraagt enkele dagen, buiten de bloedbaan is het veel langer. Macrofagen spelen een rol bij niet-specifieke en specifieke immuniteit. Ze ruimen dode cellen op en kunnen gefagocyteerde antigenen aanbieden aan B- en T-lymfocyten, zodat deze immuniteit te weeg kunnen brengen.
lichaamsholten en behoren tot het mononucleaire fagocytensysteem. Via diapedese dringen ze door de wand van capillairen en venulen, waarna zij in het bindweefsel tot actieve macrofagen differentiëren. Hierbij neemt het volume en het aantal lysosomen toe. De halfwaardetijd in het perifere bloed bedraagt enkele dagen, buiten de bloedbaan is het veel langer. Macrofagen spelen een rol bij niet-specifieke en specifieke immuniteit. Ze ruimen dode cellen op en kunnen gefagocyteerde antigenen aanbieden aan B- en T-lymfocyten, zodat deze immuniteit te weeg kunnen brengen.
E. Lymfocyten[1]
Staat aan de basis van de specifieke immunologische afweer, tegen o.a. micro-organismen, vreemde macromoleculen en mogelijk ook kankercellen. In het perifere bloed komen vooral kleine lymfocyten (6-9 µm) voor. Middelgrote en grote lymofcyten zijn specifiek door antigeen geactiveerde cellen die verder zullen differentiëren tot effector T- of B-lymfocyten. Kleine lymfocyten hebben een ronde kern met soms een geringe indeuking. Het chromatine is gecondenseerd in grove brokken heterochromatine en er is een nucleolus. Het cytoplasma vormt een smalle, licht basofiele zoom om de kern en bevat alleen wat ribosomen en kleine mitochondriën. B- en T-lymfocyten hebben een korte verblijfsduur in het bloed. Via speciale bloedvaten (hoog-endotheelvenulen) in de lymfoïde organen verlaten ze het bloed om enkele dagen deel uit te maken van de B- en T-celpopulaties van dat orgaan. Daarna keren ze via efferente lymfevaten of direct (milt) weer terug in het bloed. Deze recirculatie verhoogt de kans een passend antigeen te ontmoeten (surveillancefunctie) en het leidt tot adequate distributie van ‘memory cellen’.
Producten en functies van bloedcellen[1]
Celtype | Belangrijkste producten | Belangrijkste functies |
Erytrocyt | Hemoglobine | CO2- en O2-transport |
Leukocyt | Afweer tegen vreemde materie | |
- Neutrofiel | Specifieke granula en niet-specifieke (azurofiele) granula (gemodificeerde lysosomen) | Fagocytose van bacteriën |
- Eosinofiel | Specifieke granula, farmacologisch actieve stoffen | Afweer tegen parasitaire wormen, modulatie van ontstekingsreactie |
- Basofiel | Specifieke granula (histamine, heparine) | Afgifte van histaminen en andere ontstekingsmodulatoren |
- Monocyt | Granula met lysosomale enzymen | Basis voor mononucleaire-fagocytensysteem in periferie; fagocytose en vertering van protozoa, viruspartikels en verouderde cellen |
- B-lymfocyt | Immunoglobulinen | Vorming van antilichaamvormende plasmacellen |
- T-lymfocyt | Stoffen die andere cellen doden; stoffen die de activiteit van andere leukocyten controleren (interleukinen) | Doden van virusgeïnfecteerde cellen |
Natural killer cel (heeft geen B- of T-cel-merkers) | Stoffen die andere cellen doden; actief zonder voorafgaande stimulering | Doden van sommige virusgeïnfecteerde cellen en tumorcellen |
Bloedplaatje | Stollingsfactoren | Bloedstolling |
Een fraaie video van een bacterie fagocyterende granulocyt is hier te downloaden. Het is helaas niet zelf gemaakt maar afkomstig van Youtube. Klik op de afbeelding om het filmpje te starten.
Bloedcellen: Kleuring van bloedcellen
In het midden van een bloeduitstrijkje zijn het cytoplasma en de kern goed zichtbaar, grotere leukocyten bevinden zich vooral aan de randen.
Aan het einde van de 19e eeuw ontwikkelde Romanowsky een kleuring met methyleenblauw, azuren (oxidatieproducten van het methyleenblauw) en eosine.
Varianten zijn de mengsels van Giemsa (vrijwel overal in West-Europa gebruikt), Wright of Leishman. De Giemsa kleuring zal in dit preparaat worden uitgevoerd. Verschillende kleuringskenmerken:
1. Affiniteit voor methyleenblauw (basisch): basofilie.
2. Affiniteit voor azuren: azurofilie.
3. Affiniteit voor eosine (zuur): acidofilie of eosinofilie.
4. Affiniteit voor meerdere kleurstoffen: neutrofilie (zalmkleurig tot lila).
Onderstaande tekening geeft aan hoe een druppel bloed uitgestreken wordt op een objectglaasje. Belangrijk is dat het bloed door het tweede objectglaasje wordt meegetrokken en dus niet voortgeduwd, anders zouden alle bloedcellen kapot gedrukt worden. Het voortbewegen van het glas moet vrij snel gebeuren maar vooral met een éénparige snelheid. Zo kan een dunne laag worden verkregen. De beste plekken om te bekijken zijn de randen en de vlag (laatste deel van de uitstrijk).

De procedure nogmaals in beeld,
 | Druppel bloed aanbrengen. |
 | Tweede objectglas aanbrengen en langzaam tegen de druppel aanschuiven. |
 | Druppel tot aan rand laten uitvloeien. |
 | De druppel met een éénparige beweging uitstrijken. |
 | Tot aan de rand doorgaan met uitsmeren. |
 | Preparaat een uur aan buitenlucht laten drogen. |
Klik op de afbeeldingen,
Bronvermelding:
[1] Junqueira L.C. en Carneiro J. (2004, tiende druk), Functionele histologie, Maarssen. Uitgeverij Elsevier. Hoofdstuk 13, vanaf pag. 297, 'Bloed en bloedcellen'.
[2] Prof. Dr. med. Max Clara (1974), Atlas der normalen mikroskopischen Anatomie des Menschen, Uitgeverij Urban&Schwarzenberg. pag. 271, 'Die korpuskulären Bestandteile des peripheren Blutes'.